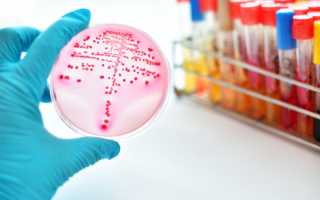
Дифтерия

Общие сведения
Дифтерия известна с давних времен и упоминается в работах таких ученых, как Гиппократ и Галена. Ранее это заболевание называли крупом, злокачественной ангиной или дифтеритом. В этой статье мы расскажем о симптомах, методах лечения и профилактике дифтерии.
Эффективность лечения дифтерии во многом зависит от антитоксина, который получают из сыворотки крови животных, перенесших это заболевание. Благодаря исследованиям Эмиля Ру и Эмиля Беринга была разработана антитоксическая противодифтерийная сыворотка. С её помощью уровень смертности от дифтерии удалось сократить с 60-70% до 1-2%.
В настоящее время для профилактики дифтерии используется вакцина, созданная Гастоном Рамоном, учеником Ру.
Врачи подчеркивают, что дифтерия остается серьезной инфекцией, несмотря на значительное снижение заболеваемости благодаря вакцинации. Специалисты отмечают, что болезнь может проявляться не только в виде классических симптомов, таких как боль в горле и образование налета на миндалинах, но и вызывать осложнения, включая поражение сердца и нервной системы. Врачи призывают родителей следить за графиком прививок своих детей, так как вакцинация является наиболее эффективным способом профилактики. Они также акцентируют внимание на важности ранней диагностики и своевременного лечения, так как это может существенно снизить риск тяжелых последствий. В условиях глобализации и миграции населения риск повторного возникновения вспышек остается высоким, что требует постоянного мониторинга и готовности медицинских учреждений.

Причины
Дифтерия вызывается дифтерийной палочкой — грамположительной бактерией. Этот микроорганизм производит экзотоксин, который относится к мощным бактериальным ядам, таким как ботулотоксин и токсин, вызывающий столбняк.
| Симптом | Тяжесть | Возможные осложнения |
|---|---|---|
| Налет на миндалинах и задней стенке глотки | Легкая — тяжелая | Миокардит, полиневрит, поражение почек |
| Отек шеи («бычья шея») | Легкая — тяжелая | Асфиксия, сепсис |
| Лихорадка | Легкая — тяжелая | Повреждение сердца, нервной системы |
| Слабость, утомляемость | Легкая — тяжелая | Длительная слабость, инвалидность |
| Боль в горле | Легкая — тяжелая | |
| Затрудненное дыхание | Легкая — тяжелая | Пневмония, дыхательная недостаточность |
| Нарушение глотания | Легкая — тяжелая | Обезвоживание |
Он состоит из нескольких компонентов:
- Гиалуронидаза — фермент, который разрушает стенки капилляров. Это приводит к повышенной проницаемости сосудов и накоплению белка фибриногена в окружающих тканях из сыворотки крови.
- Некротоксин — повреждает эпителиальные клетки, из которых выделяется тромбокиназа. Эта молекула способствует образованию фибрина из фибриногена, что приводит к образованию характерных пленок.
- Основной токсин — угнетает клеточное дыхание и синтез белков. Его влияние особенно заметно в мелких сосудах, нервных клетках и сердечной мышце. Тяжесть заболевания во многом зависит от действия этого токсина.
Механизм передачи инфекции — от больного человека или здорового носителя. Особенно опасны пациенты с неявными симптомами или атипичным течением болезни.
Дифтерия — это инфекционное заболевание, которое вызывает множество обсуждений среди людей. Многие вспоминают о ней как о болезни, которая была распространена в прошлом, но с появлением вакцин ее случаи значительно сократились. Тем не менее, некоторые все еще опасаются вспышек, особенно в регионах с низким уровнем вакцинации. Люди делятся своими историями о том, как их близкие страдали от этой болезни, и подчеркивают важность прививок для защиты здоровья. В социальных сетях можно встретить мнения о необходимости повышения осведомленности о дифтерии, особенно среди молодежи, чтобы предотвратить возможные случаи заболевания. Некоторые родители выражают беспокойство о безопасности вакцин, но большинство медицинских специалистов настаивают на их эффективности и необходимости. В целом, дифтерия остается актуальной темой, вызывающей интерес и обсуждение в обществе.

Передается болезнь тремя путями:
- воздушно-капельным путем (при общении, кашле);
- контактно-бытовым способом;
- через пищу (при употреблении зараженных продуктов).
Бактерия, вызывающая дифтерию, может выделяться в течение 15-20 дней, а у выздоровевших — до 3 месяцев.
Классификация

Заболевание различается по форме, выделяют такие ее разновидности:
Дифтерия ротоглотки подразделяется на несколько типов:
- локализованная;
- распространенная;
- субтоксическая;
- токсическая;
- гипертоксическая;
- дифтерийный круп;
- другие формы, включая поражения глаз, носа, половых органов и кожи;
- комбинированная форма.
Наиболее часто встречается локализованная форма, которая диагностируется в 90-95% случаев и является самой распространенной.
Симптомы дифтерии
Классическая дифтерия (ротоглотки) характеризуется:
- повышение температуры (обычно не превышает 38ºС);
- общая интоксикация (потеря аппетита, учащенное сердцебиение, слабость, головная боль, бледность кожи);
- налет на пораженной слизистой: сначала белый и рыхлый, затем серовато-белый, плотный и гладкий;
- умеренная или сильная боль в горле при глотании;
- увеличение и чувствительность регионарных лимфоузлов;
- отек шеи.
Степень тяжести интоксикации варьируется в зависимости от уровня токсического поражения, общего состояния организма и наличия сопутствующих заболеваний.
При дифтерийном крупе затрагиваются слизистые оболочки гортани, трахеи или бронхов. Основные симптомы включают:
- кашель (сухой, напоминающий «лающий»);
- нарастающая осиплость голоса;
- прогрессирующая афония (потеря звучности голоса);
- затрудненное дыхание с характерными шумами, возможна асфиксия.
Дифтерия носа проявляется более легкими симптомами. Температура может не повышаться или быть незначительной, а общая интоксикация выражена слабо. Дыхание через нос затруднено, слизистая оболочка покрыта язвами и характерным налетом.
Дифтерия глаз напоминает классический конъюнктивит, на воспаленных участках может образовываться налет – серозно-гнойные выделения.
Дифтерия половых органов проявляется отеком и покраснением крайней плоти и головки полового члена (у мужчин), половых губ и влагалища (у женщин). Образуется характерный фибринозный налет, у женщин могут наблюдаться геморрагические выделения.
Кожные покровы могут инфицироваться при нарушении их целостности. Дифтерийная палочка «приживается» на ссадинах, ранах и повреждениях грибковой природы. Дифтерия кожи также сопровождается типичным фибринозным налетом.
Диагностика дифтерии
Комплекс диагностических мероприятий:
- Обследование пациента и сбор медицинской истории.
- Общий анализ крови для выявления и оценки воспалительного процесса.
- Мазок с пораженных слизистых (горла, носа, глаз и других) с последующим бактериологическим посевом.
- ПЦР-диагностика как дополнительный метод для уточнения уровня антитоксических антител.
При выраженной интоксикации и осложнениях необходимы консультации специалистов, таких как невролог и кардиолог, а также проведение специфических исследований, например, УЗИ сердца и электрокардиограммы.
Лечение дифтерии
Лечение дифтерии должно проводиться в специализированных медицинских учреждениях, обычно в инфекционных отделениях больниц. Основным методом терапии является введение противодифтерийной антитоксической сыворотки. Чем раньше начнется ее применение, тем эффективнее будет лечение.
Кроме этого для лечения назначают:
- дезинтоксикационные растворы;
- антигистаминные средства;
- витаминные комплексы;
- антибиотики (для предотвращения вторичной бактериальной инфекции).
При токсической и гипертоксической формах заболевания рекомендуется плазмаферез. Рассматриваются также гемосорбция и иммуносорбция. Назначаются гормональные препараты для устранения недостаточности коры надпочечников.
Важно регулярно проветривать и проводить влажную уборку в помещении, где находится пациент. Рекомендуются паровые ингаляции и теплое питье.
При гипоксии назначается оксигенотерапия. Дыхательная недостаточность и тахипноэ, превышающие 40 дыхательных движений в минуту, требуют интубации трахеи или трахеостомии с последующей искусственной вентиляцией легких.
Профилактика дифтерии
Основной мерой профилактики дифтерии является вакцинация. Первые прививки (трижды вводимая вакцина с интервалом в один месяц) рекомендуются с трехмесячного возраста. Это позволяет организму подготовиться к встрече с дифтерийной палочкой, когда естественный иммунитет, полученный от матери, начинает угасать к шести месяцам. Ревакцинация проводится в возрасте 6, 11 и 16 лет.
Среди привитых детей, составляющих 97-98%, случаи заболевания практически не фиксируются или наблюдаются лишь единичные эпизоды.
Повторная вакцинация важна и для взрослых, особенно для тех, кто работает в следующих сферах:
- образовательные учреждения (школы и детские сады);
- сфера обслуживания;
- медицинские учреждения;
- высшие учебные заведения (включая студентов, особенно проживающих в общежитиях).
При подтверждении диагноза принимаются следующие профилактические меры:
- госпитализация и изоляция пациента;
- выявление носителей дифтерийной палочки среди близкого окружения;
- дезинфекция личных вещей больного и проведение влажной уборки с использованием антисептиков.
Прогноз
Легкая и умеренная форма локализованной дифтерии обычно имеет благоприятный прогноз. Токсические разновидности протекают тяжелее, особенно при присоединении вторичных инфекций, позднем выявлении симптомов и несвоевременном начале лечения. В таких случаях возможны осложнения, затрагивающие дыхательную систему, сердце, почки и нервную систему. Хотя вероятность летального исхода остается низкой, он все же возможен. На сегодняшний день такие случаи составляют 5% от общего числа заболевших.
Вопрос-ответ
Что такое дифтерия простыми словами?
Дифтерия – это острое инфекционное заболевание, возбудителем которого выступает токсигенная коринебактерия. Болезнь опасна развитием дыхательной недостаточности, изменениями в сердце, нервной системе, почках, надпочечниках под воздействием токсина. Заболевание может закончиться летально.
Какие симптомы у болезни дифтерии?
Симптомы дифтерии. Болезнь начинается с повышения температуры и слабости. Кроме того, наблюдается следующая симптоматика: отек слизистой ротоглотки и шеи, серо-белый налет на миндалинах, увеличение подчелюстных и шейных лимфоузлов.
В чем разница между дифтерией и ангиной?
При дифтерии в воспалительный процесс вовлекается небо, а при ангине поражаются только миндалины.
Советы
СОВЕТ №1
Регулярно проверяйте свой статус вакцинации. Дифтерия — это инфекционное заболевание, от которого можно защититься с помощью прививок. Убедитесь, что вы и ваши дети получили все необходимые вакцины в соответствии с национальным календарем прививок.
СОВЕТ №2
Обратите внимание на симптомы. Если вы или ваши близкие заметили такие признаки, как боль в горле, затрудненное дыхание или образование пленки на миндалинах, немедленно обратитесь к врачу. Раннее выявление и лечение могут предотвратить серьезные осложнения.
СОВЕТ №3
Соблюдайте правила гигиены. Частое мытье рук, использование антисептиков и избегание близкого контакта с больными людьми помогут снизить риск заражения дифтерией и другими инфекциями.
СОВЕТ №4
Информируйте себя о вспышках заболеваний. Следите за новостями и рекомендациями местных органов здравоохранения, особенно в период эпидемий. Это поможет вам принимать обоснованные решения о профилактике и защите себя и своей семьи.